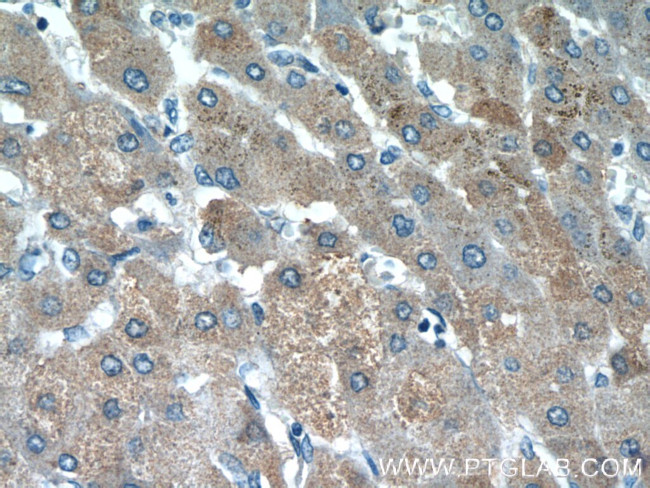
HSPC159 Antibody in Immunohistochemistry (Paraffin) (IHC (P))

Search
Proteintech
HSPC159 Polyclonal Antibody
{{$productOrderCtrl.translations['antibody.pdp.commerceCard.promotion.promotions']}}
{{$productOrderCtrl.translations['antibody.pdp.commerceCard.promotion.viewpromo']}}
{{$productOrderCtrl.translations['antibody.pdp.commerceCard.promotion.promocode']}}: {{promo.promoCode}} {{promo.promoTitle}} {{promo.promoDescription}}. {{$productOrderCtrl.translations['antibody.pdp.commerceCard.promotion.learnmore']}}
产品信息
16708-1-AP
种属反应
宿主/亚型
分类
类型
抗原
偶联物
形式
浓度
规格
纯化类型
保存液
内含物
保存条件
运输条件
产品详细信息
Immunogen sequence: MAGSVADSDA VVKLDDGHLN NSLSSPVQAD VYFPRLIVPF CGHIKGGMRP GKKVLVMGIV DLNPESFAIS LTCGDSEDPP ADVAIELKAV FTDRQLLRNS CISGERGEEQ SAIPYFPFIP DQPFRVEILC EHPRFRVFVD GHQLFDFYHR IQTLSAIDTI KINGDLQITK LG
靶标信息
Does not bind lactose, and may not bind carbohydrates.
仅用于科研。不用于诊断过程。未经明确授权不得转售。
篇参考文献 (0)
生物信息学
蛋白别名: Galectin-like protein; Galectin-related protein; Galectin-related protein A; Lectin galactoside-binding-like protein; Lectin galactoside-binding-like protein A; lectin, galactoside binding like; unnamed protein product
基因别名: 1110067D22Rik; A530071M23; GRP; Grpa; HSPC159; LGALSL; Lgalsla; RGD1307414
UniProt ID: (Human) Q3ZCW2, (Mouse) Q8VED9
Entrez Gene ID: (Pig) 100270690, (Human) 29094, (Rat) 360983, (Mouse) 216551